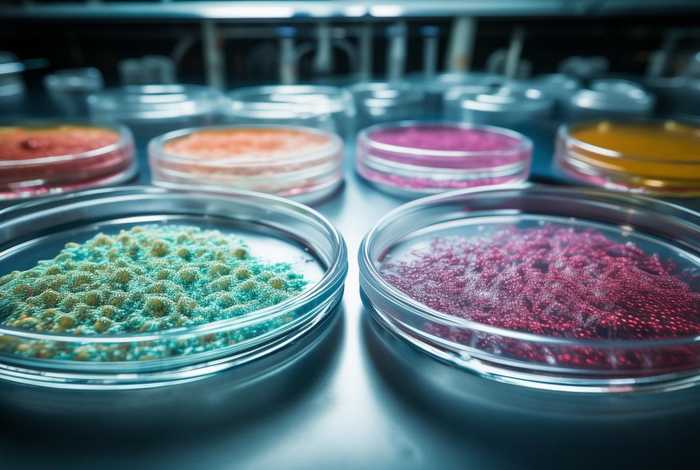
粒系增生活跃,成熟阶段细胞减少 粒系增生活跃,成熟阶段细胞减少严重吗

粒系增生活跃,成熟阶段细胞减少 粒系增生活跃,成熟阶段细胞减少严重吗
-
粒系,增生,活跃,成熟,阶段,细胞,减少,严重,吗,

- 生活-自由百科知识生网
- 2026-03-10 07:16
- 自由百科知识网
粒系增生活跃,成熟阶段细胞减少 粒系增生活跃,成熟阶段细胞减少严重吗 ,对于想学习百科知识的朋友们来说,粒系增生活跃,成熟阶段细胞减少 粒系增生活跃,成熟阶段细胞减少严重吗是一个非常想了解的问题,下面小编就带领大家看看这个问题。
当的"青年军"暴增而"成熟战士"消失——这有多危险?
在人体这座精密工厂里,如同血细胞的"育儿所",每天生产着2000亿个新生细胞。但当体检报告显示"粒系增生活跃却成熟细胞减少"时,意味着生产线出现了诡异失衡——年轻细胞疯狂增殖,却难以成长为合格战士。这种看似矛盾的病理现象,可能是血液系统发出的第一道烽火狼烟。
一、病理本质:造血流水线故障
粒系就像汽车组装车间,干细胞经过原粒、早幼粒、中幼粒等"工序"逐步成熟。当检测显示早中期细胞占比超65%(正常应<30%),而分叶核粒细胞骤减,提示细胞在"青春期"发生大规模滞留。
这种现象常见于异常增生综合征(MDS)早期,如同工厂新招大量学徒工,却缺乏老师傅带教。更危险的是,约22%的急性髓系白血病前期会呈现此类特征,那些停滞发育的"半成品"细胞可能突变为癌细胞。
值得注意的是,某些感染或药物反应也会引发类似改变。就像车间为应对突发订单临时扩招工人,这种一过性变化通常在诱因解除后2-3周恢复正常,与恶性疾病的持续恶化存在本质区别。
二、临床症状:从隐匿到爆发
早期可能仅表现为反复低烧或轻微乏力,如同生锈的水管缓慢渗漏。随着成熟粒细胞(人体免疫主力军)持续短缺,患者会陷入"三连击"困境:
• 感染风暴:口腔溃疡久治不愈,肺炎频发,甚至出现罕见真菌感染。数据显示,中性粒细胞<0.5×10⁹/L时,48小时内发生败血症风险提升8倍。
• 出血危机:血小板生成常伴随受影响,皮肤淤青像午夜蓝莓般突然浮现,刷牙时牙龈渗血可能持续20分钟以上。
• 缺氧循环:代偿性增生的幼稚细胞挤占红细胞"生产线",患者爬半层楼就气喘如牛,面色呈现特有的"蜡烛黄"。
最令人警惕的是"无症状窗口期",有些患者血常规仅显示轻度贫血,穿刺却已揭示危机,这正是年度体检必须包含血涂片检查的原因。
三、诊断迷宫:抽丝剥茧的侦查
精准判断需要"四维诊断法":活检如同犯罪现场勘查,流式细胞术则像DNA检测,能发现CD34+祖细胞上的异常标记物。最新研究显示,NGS基因检测可提前6-18个月预警恶变风险。
临床常见三大诊断陷阱:

1. 与类白血病反应混淆:严重烧伤或中毒时也可能出现幼稚细胞升高,但通常伴随CRP值爆表
2. 纤维化干扰:增生的纤维组织像蜘蛛网般包裹细胞,导致穿刺出现"干抽"假象
3. 检验标准差异:部分医院仍在使用1998年FAB分型标准,而WHO新标准将原始细胞≥20%才定为白血病,中间状态的判定需要经验丰富的血液科医师掌舵
建议确诊前完成"黄金组合检查":活检+染色体核型分析+至少42种白血病相关基因筛查,这套组合拳的诊断准确率达92.7%。
四、治疗策略:精准医学的战场
对于低危组患者,促分化治疗如同细胞"成长导师"。全反式维甲酸(ATRA)能让80%的早幼粒白血病细胞改邪归正,而G-CSF生长因子则像细胞军训教官,督促幼稚粒细胞完成成熟训练。
中高危组需要更激进的手段:
• 去甲基化药物(如地西他滨)如同基因"橡皮擦",能抹去癌细胞上的异常化学标记
• 异基因移植是终极解决方案,但需要跨越"移植物抗宿主病"的死亡峡谷,最新采用的半相合移植技术将供体范围扩大至父母子女
• 靶向药Venetoclax能精准引爆BCL-2蛋白这个"细胞自杀开关",2024年临床试验显示联合用药可使5年生存率提升至61%
特别提醒:盲目使用"升白针"可能火上浇油。某三甲医院曾收治患者自行注射G-CSF后,原始细胞两周内从5%飙升至28%,如同给叛乱分子空投武器。
五、预后密码:藏在基因里的答案
TP53基因突变是著名的"死亡预言",携带者中位生存期仅9个月。而单独存在的SF3B1突变则相对温和,如同癌症世界的"慢车道"。国际预后评分系统(IPSS-R)将患者分为五个等级:
• 极低危组:10年生存率83%,基本不影响自然寿命
• 极高危组:2年内白血病转化率79%,需要争分夺秒治疗
• 关键转折点:当原始细胞突破10%门槛,疾病会像雪崩般加速恶化
最新发表在《Blood》的研究指出,定期监测外周血中的循环肿瘤DNA(ctDNA),比穿刺能早3-4个月发现病情进展,这种"液体活检"技术正改写监测标准。
生命沙漏里的细沙——我们能抓住多少?
粒系发育失衡就像人体内的"沙漏异常",年轻细胞不断堆积在上层,而成熟细胞如细沙般从底部流逝。这种动态平衡的打破可能是暂时警报,也可能是灾难前兆。
建议40岁以上人群每年进行血常规+血涂片筛查,当发现持续中性粒细胞减少合并单核细胞升高时,务必在72小时内完成检查。记住,在血液疾病领域,早一天诊断可能意味着多赢得三年生存期——这不仅是医学问题,更是生命与时间的哲学博弈。
以上是关于粒系增生活跃,成熟阶段细胞减少 粒系增生活跃,成熟阶段细胞减少严重吗的介绍,希望对想学习百科知识的朋友们有所帮助。
本文标题:粒系增生活跃,成熟阶段细胞减少 粒系增生活跃,成熟阶段细胞减少严重吗;本文链接:https://yszs.weipeng.cc/sh/740682.html。
猜你喜欢
- 粒系增生活跃,红系增生减低严重吗;粒系增生活跃,红系增生减低严重吗怎么治疗 2026-03-10
- 粒系增生活跃,占比72 增生活跃,粒系65%,红系17% 2026-03-10
- 粒系增生明显活跃(粒系增生明显活跃是癌症吗) 2026-03-10
- 粒系增生减低,巨系成熟障碍,可见3%幼稚样淋巴细胞(幼稚及成熟粒细胞群) 2026-03-10
- 穿刺结果显示增生活跃粒 - 穿刺结果显示增生活跃粒细胞高 2026-03-09
- 穿刺增生活跃(穿刺增生活跃严重吗) 2026-03-09
- 病理细胞增生活跃 - 病理细胞增生活跃是癌吗 2026-03-07
- 活跃性增生 活跃性增生怎么治疗 2026-03-02
- 次造血组织增生活跃幼红细胞增生、造血组织增生不均一,粒系增生活跃,幼红细胞偏高 2026-03-01
- 核细胞增生活跃(核细胞增生明显活跃) 2026-02-28














